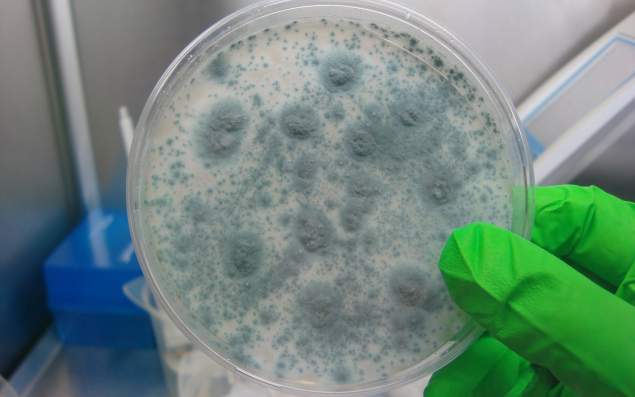

La genèse
Ademtech a été fondée en 2000 par un groupe de scientifiques issus du Centre Paul Pascal, laboratoire du CNRS situé à Pessac (Gironde). Ils ont « mis au point une synthèse de particules magnétiques, technologie brevetée et protégée », résume Sandrine Godichaud, directrice marketing. Après trois années de R & D, la société (18 salariés, 1,23 M€ de chiffres d’affaires en 2018), présidée par Bernard Plichon et nichée au sein du Bioparc Bordeaux Métropole, entre dans la phase de commercialisation. Au départ, ses clients étaient des laboratoires de recherche ou des entreprises spécialisées dans les diagnostics d’immunologie.
Le concept
« Au fur et à mesure de nos développements et de nos collaborations, nous avons eu l’idée d’utiliser les billes magnétiques pour la capture d’acide nucléique, dans le cadre de la médecine légale et de l’extraction d’ADN pour l’identification génétique en criminologie », reprend Sandrine Godichaud. Aujourd’hui, ces produits, principalement utilisés par la police et la gendarmerie, représentent 48 % de notre chiffre d’affaires ». Ils ont par exemple permis d’identifier les passagers victimes du crash de l’avion de la compagnie Germanwings dans les Alpes en mars 2015.
Après avoir décroché le marché de la Gendarmerie nationale en 2015, c’est l’appel d’offres de la police scientifique qu’a obtenu Ademtech en 2018. « Nos billes magnétiques sont plus petites que les autres sur le marché. Elles capturent plus d’ADN et moins de matières que l’on ne souhaite pas retrouver. Sur du cuir, des jeans, on retrouve souvent des substances et colorants qui empêchent de détecter l’ADN. Notre technologie nous permet d’éliminer ces substances. »
Une petite partie de l’activité provient d’un marché qu'Ademtech a commencé à adresser en 2015 : le diagnostic d’infection fongique et parasitaire. « Nous créons des kits à destination des hôpitaux et des laboratoires pour identifier un champignon ou un parasite, par exemple pour des patients ayant voyagé à l’étranger », décrit la directrice marketing.
Les perspectives
Pour financer son développement, Ademtech vient de lancer une levée de fonds par le biais de la plateforme bordelaise de financement participatif Happy Capital. « Ces moyens supplémentaires nous permettront de nous développer à l’export. En particulier en matière de génétique humaine, pour les polices et gendarmeries, donc. » En France, l’entreprise représente 75 % du marché. À l’étranger, elle a décroché un appel d’offres en Estonie et est aussi présente aux Pays-Bas. Elle envisage deux à trois recrutements et affiche des objectifs élevés : 2 M€ de chiffre d’affaires cette année, 8 M€ en 2025.